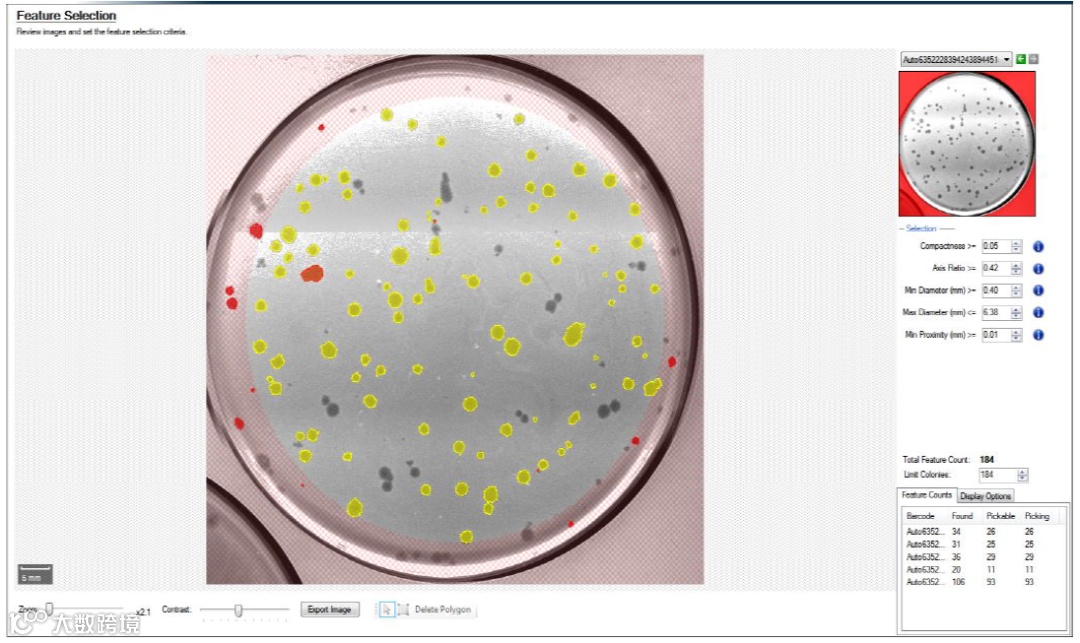
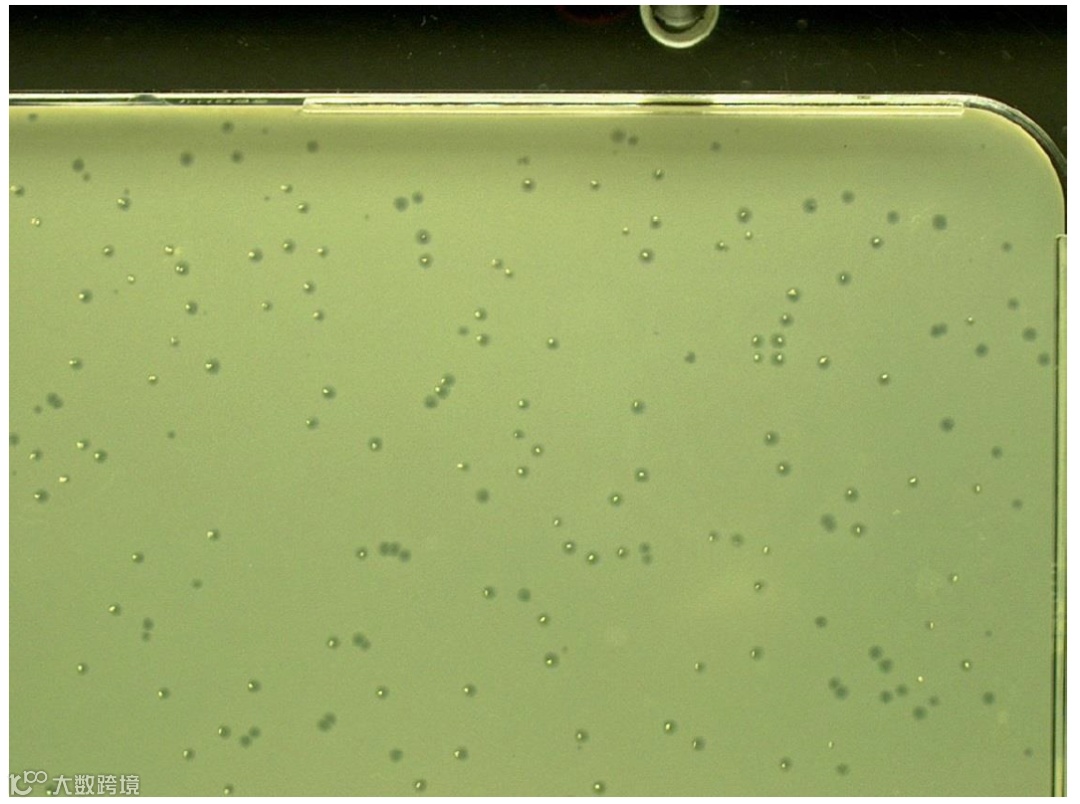

背景
过去几十年中,单抗治疗在癌症,自身免疫病等疾病中得到广泛应用。随着科学进步,抗体的发现和分离手段也不断更新,包括杂交瘤技术,转基因动物,重组 DNA 技术,B 细胞分离技术以及噬菌体展示技术等。尽管最先出现的杂交瘤技术曾是抗体发现中的半壁江山,噬菌体展示技术仍然凭借着高通量,简便,快速的特点在激烈竞争中脱颖而出,成为当前抗体发现非常的重要手段。
噬菌体展示是一种用于研究蛋白质-蛋白质,蛋白质-多肽,蛋白质-DNA 相互作用的技术。利用基因工程的方法将编码目的蛋白或者多肽的 DNA 与编码噬菌体外壳蛋白的 DNA 融合,最终将目标蛋白以融合蛋白的形式展示在噬菌体的表面,然后使用亲和选择的方法选择展示目标蛋白或多肽的噬菌体,通过测序得到目标序列后在进行下游的基因工程改造。其最大的优势在于将抗体的基因型和表型联系起来,快速、低成本、高通量地进行抗原筛选。
噬菌体展示技术由乔治·P·史密斯在 1985 年首次创建,并且凭借此在 2018 年获得了诺贝尔化学奖。1990 年 Mc Cafferty 利用噬菌体展示技术生产重组蛋白[1],之后该技术在全世界范围内得到广泛应用,其中最成功的应用是进行抗体展示。第一个获得 FDA 批准的 PD-L1 抗体 Atezolizumab 就是通过噬菌体展示技术筛选得到的。目前用于抗体发现技术的主要是丝状噬菌体 M13,它能够将单链 DNA 包装成病毒颗粒,在不引起细胞裂解的情况下感染细菌,该特性允许研究人员使用噬菌体 M13 在病毒表面显示外源肽或蛋白质,使其适应各种应用,例如抗体生产,药物筛选和疫苗开发。


实验步骤



QPix 在噬菌体
展示实验中的应用



展望

参考文献
[1] L Ledsgaard et al., Advances in antibody phage display technology. Drug Discov Today, 2022. 27(8): 2151–2169.
[2] Kumar, R et al., Phage display antibody libraries: A robust approach for generation of recombinant human monoclonal antibodies. Int J Biol Macromol, 135, 907–918.
[3] Ratnikov B et al., High Throughput Substrate Phage Display for Protease Profiling. Methods in Molecular Biology, 2009. 539(539):93-114.
[4] Turunen Let al., Automated panning and screening procedure on microplates for antibody generation from phage display libraries. Journal of Biomolecular Screening, 2009. 14(14):282-93.
关于美谷分子仪器
Molecular Devices 始创于上世纪 80 年代美国硅谷,并在全球设有多个代表处和子公司。2005 年,Molecular Devices 在上海设立了中国代表处,2010 年加入全球科学与技术的创新者丹纳赫集团,2011 年正式成立商务公司:美谷分子仪器 (上海) 有限公司。Molecular Devices 以持续创新、快速高效、高性能的产品及完善的售后服务著称业内,我们一直致力于为客户提供在生命科学研究、制药及生物治疗开发等领域蛋白和细胞生物学的创新性生物分析解决方案。